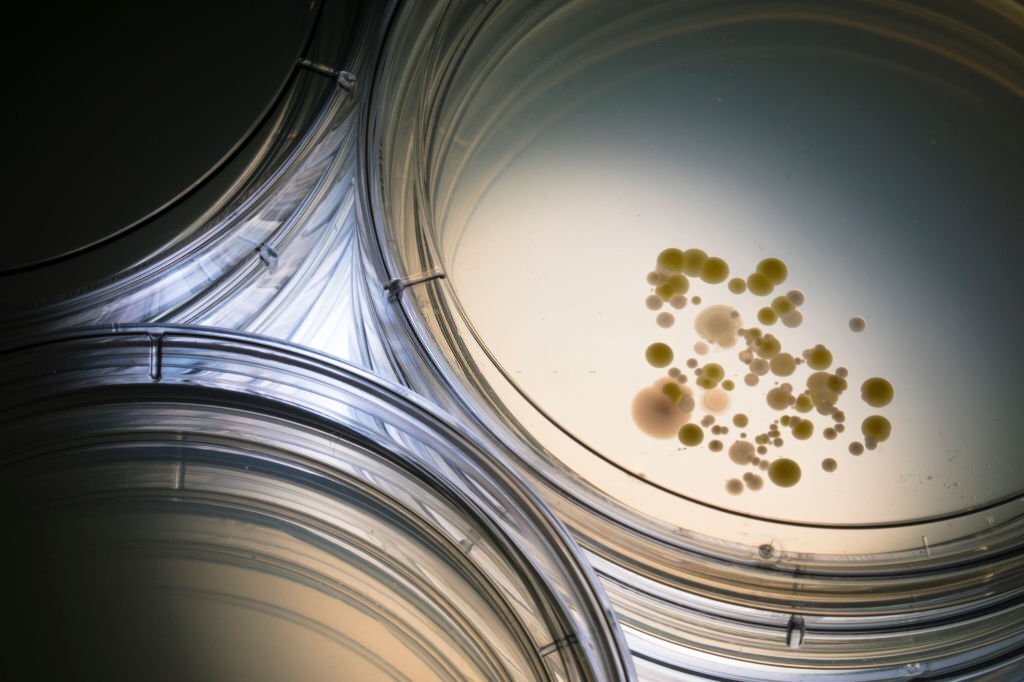

从原材料的检测,到生产环节的优化,海运仓储的防潮防霉,全方位保护您的产品
 产品优势
产品优势
-
自主研发
自主研发阳离子防霉抗菌剂、 自主研发抗菌新材料、 制定防霉与抗菌行业标准等
-
厂家优势
自主研发、生产,具备BSL-2实验室与消字号生产车间、干燥剂生产 车间等等,支持灵活定制、开版印刷、配方研发等等
-
专注微生物防护
业内首家备BSL-2研发实验室,为客户提供更标准的防霉与抗菌的效果检测与成分研发
-
质量可靠性高
我们拥有行业内资深的技术工程师,可为您一对一提供工业防霉抗菌完全解决方案!
-
商业模式灵活
多层次、全方位的合作与支持服务